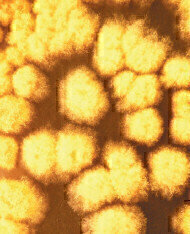
Breaking the Mould

Laboratory products
Breaking the Mould
Apr 14 2011
Battling yeast and mould contamination in foodstuffs requires specialist culture media and Lab M has added Dichloran 18% Glycerol Agar (DG18 Agar) ISO to the armoury. Designed specifically to enhance the growth of viable osmophilic yeasts and xerophilic moulds from low water activity environments, this complete formulation requires no additional supplementation, minimising media preparation time and reducing procurement needs and costs. DG18 complies both with current ISO requirements and methods set out in the Bacteriological Analytical Manual (BAM), supporting testing laboratories in achieving their quality standards. Complementing DG18 is Lab M’s Dichloran Rose Bengal Chloramphenicol Agar (ISO), which is designed for the enumeration of viable yeasts and moulds in products with a higher water activity - above 0.95. It too is quick and easy to make up, requiring no additional supplementation. Prepared according to ISO 21527-1:2008 it complies with BAM, as well as American Public Health Association (APHA), methods.
Digital Edition
Lab Asia Dec 2025
December 2025
Chromatography Articles- Cutting-edge sample preparation tools help laboratories to stay ahead of the curveMass Spectrometry & Spectroscopy Articles- Unlocking the complexity of metabolomics: Pushi...
View all digital editions
Events
Jan 21 2026 Tokyo, Japan
Jan 28 2026 Tokyo, Japan
Jan 29 2026 New Delhi, India
Feb 07 2026 Boston, MA, USA
Asia Pharma Expo/Asia Lab Expo
Feb 12 2026 Dhaka, Bangladesh